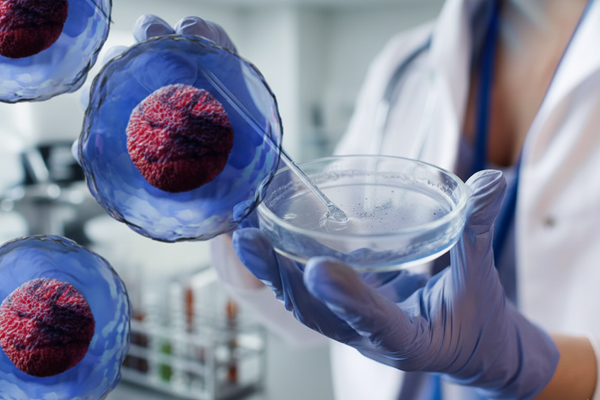
Tratamiento de células madre CDMX

Tratamiento con Células Madre
Más de 16 años de experiencia aplicando tratamientos celulares con casos documentados. Conoce cómo este tratamiento puede apoyar procesos de recuperación y bienestar.
Atención profesional y valoración individual.
Atención profesional y valoración individual.
 Procesos con enfoque clínico.
Procesos con enfoque clínico.
¿Qué se puede tratar?
- Diabetes
- Artritis
- Reumatoide
- Desgaste articular
- Lupus
- Esclerosis múltiple
- Dolor neuropático
- Parkinson
- Alzheimer
- Migraña
- Fatiga crónica
- Fibromialgia
- Lyme
- Autismo
- Trastornos metabólicos
- Dolor crónico
- Otras afecciones autoinmunes
- Entre otros
 La indicación depende de una valoración médica individual.
La indicación depende de una valoración médica individual.
¿Cómo funcionan?
Recambio celular
Apoyan la generación de células sanas para reemplazar células dañadas.
Modulación
Participan en la regulación de respuestas del sistema inmune.
Destino tisular
Se dirigen a tejidos que requieren apoyo para su recuperación.

Diabetes – ¿Qué podemos lograr con este tratamiento?
- Regular los niveles de glucosa en sangre
- Reparar daño en órganos y vasos sanguíneos
- Mejorar los niveles metabólicos
- Frenar el avance natural de la enfermedad
- Prevenir los padecimientos consecuentes a la diabetes
- Mayor aporte de energía, mejor sueño, menos dolor e inflamación
- Mejorar la calidad de vida del paciente
 Acompañamiento y seguimiento clínico.
Acompañamiento y seguimiento clínico.
Células Madre y Desgaste Articular
El desgaste de articulaciones y las enfermedades osteodegenerativas como la artrosis provocan dolor, rigidez e inflamación. Los tratamientos con Células Madre han mostrado ser una alternativa prometedora para frenar la progresión del daño y apoyar la recuperación funcional.
 Enfoque en movilidad y función articular.
Enfoque en movilidad y función articular.
¿En qué consiste el tratamiento?
Aplicación local en la articulación dañada (aprox. 20 minutos, indolora). La cantidad de aplicaciones se determina según la valoración del especialista. En algunos casos se sugiere complementar con dosis intravenosas de Células Madre e implante placentario.
 Procedimiento ambulatorio.
Procedimiento ambulatorio.
Agenda tu Cita
Dr. Juan Macias
Poniente 25 #464, Col. La Perla, Cd. Nezahualcóyotl
